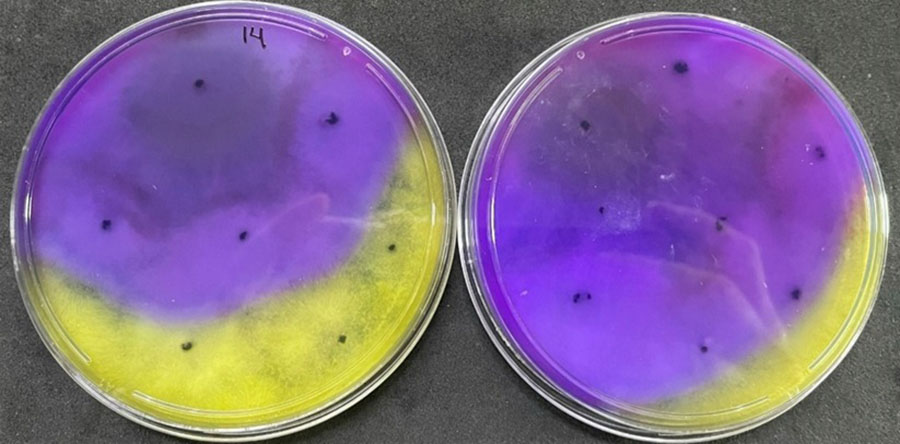

Foto: Sebastião Araújo

Mofo-branco na vagem do feijão
| Pesquisadores identificam novos fungos do gênero Trichoderma que inibem 100% o mofo-brancoDoença é uma das principais ameaças para cultivos como soja, feijão e algodão.Alternativa biológica reduz dependência de fungicidas químicos.Pesquisa destaca potencial do biocontrole e da integração com outras boas práticas agrícolas.Mercado de biopesticidas cresce com demanda por soluções sustentáveis. |
Cientistas brasileiros identificaram espécies de fungos do gênero Trichoderma capazes de eliminar completamente os escleródios (estruturas de resistência) do Sclerotinia sclerotiorum, fungo causador da doença que prejudica cultivos estratégicos como soja, feijão e algodão. Os resultados, obtidos em laboratório, indicam um novo caminho para o controle biológico da doença, historicamente combatida com fungicidas químicos de alto custo e impacto ambiental.
O estudo foi conduzido pela pesquisadora Laísy Bertanha, da Universidade Estadual Paulista (Unesp), com orientação do pesquisador da Embrapa Wagner Bettiol. A pesquisa identificou cepas de Trichoderma yunnanense e Trichoderma dorotheae que inibem até 100% a germinação do patógeno. O desempenho de destaque foi do Trichoderma yunnanense, com 97,5% de eficácia na inibição da germinação, evidenciando seu potencial para uso como biofungicida.
Os pesquisadores contam que o mofo-branco é uma doença de difícil controle devido à longa sobrevivência de seus escleródios no solo. O combate tradicionalmente depende do uso intensivo de fungicidas, que possuem alto custo, riscos ambientais e podem induzir resistência nos patógenos. A adoção de biocontrole com Trichoderma oferece uma solução mais segura e sustentável.
Segundo Bertanha, o uso combinado de diferentes cepas de Trichoderma pode aumentar a eficácia do controle biológico, reduzindo a presença da doença no solo. A pesquisa reforça a importância de isolar microrganismos no mesmo ambiente onde serão aplicados, maximizando sua capacidade de suprimir patógenos.
Imagem: Divulgação (placas com escleródios – estrutura de sobrevivência do fungo causador do mofo-branco)

O estudo se insere no crescimento do mercado de biopesticidas, impulsionado pela demanda por práticas agrícolas mais sustentáveis. O Brasil tem expandido o uso de Trichoderma no manejo de doenças desde a década de 1980, mas desafios persistem, como a produção em larga escala, a compatibilidade com práticas tradicionais e a capacitação de agricultores, explica Bettiol.
No manejo integrado de doenças, o biocontrole deve ser combinado com práticas como a rotação de culturas, que reduz a presença do patógeno no solo. A rotação com gramíneas, por exemplo, é eficaz, pois essas plantas não são hospedeiras do fungo Sclerotinia sclerotiorum, o agente causal do mofo-branco. Além disso, a adição de matéria orgânica no solo pode favorecer microrganismos benéficos, aumentando a resistência natural das áreas cultivadas.
Outra estratégia essencial no controle do mofo-branco é o uso de sementes de alta qualidade. Como a doença é monocíclica, ou seja, o inóculo inicial tem grande impacto na severidade da epidemia, o uso de sementes livres de patógenos e a sanitização de máquinas agrícolas são medidas fundamentais para evitar a dispersão do fungo, comenta Bertanha.
Imagem: Divulgação (solos colonizados pelos fungos antagonistas)

Esses agentes biológicos interferem na síntese de substâncias como o ácido oxálico, essencial para a virulência do fungo, diminuindo sua capacidade de causar infecções severas.
A seleção de microrganismos eficazes é um processo rigoroso, que envolve isolar cepas com alto potencial de controle. Durante a pesquisa, Bertanha identificou nove espécies diferentes de Trichoderma em áreas de agricultura orgânica, sendo que Trichoderma yunnanense e Trichoderma atrobrunneum se destacaram na supressão do mofo-branco.
O Trichoderma yunnanense foi isolado de solos cultivados com feijão irrigado, conta Bettiol. Ele destaca que a diversidade microbiana do solo tem relação direta com sua capacidade de suprimir patógenos, tornando o biocontrole uma ferramenta valiosa na busca por sistemas agrícolas mais equilibrados e resilientes. Pesquisas indicam que o biocontrole também pode reduzir a agressividade deste e de outros patógenos.
A efetividade do biocontrole depende da adoção de estratégias integradas, combinando biofungicidas, práticas culturais e, quando necessário, produtos químicos. “Essa abordagem permite um manejo mais eficiente do mofo-branco, reduzindo impactos ambientais e promovendo uma agricultura mais sustentável”, conclui Bettiol.
Foto: Sebastião Araújo (mofo-branco no feijão)
| A liderança brasileira nos bioinsumos O mercado global de bioinsumos agrícolas cresce, em média, 14% ao ano. No Brasil, o ritmo é ainda mais intenso: só entre 2021 e 2022, o setor cresceu 67%, segundo a Embrapa. Estima-se que o país responda por cerca de 20% do consumo mundial desses produtos.O País é o maior mercado mundial de bioinsumos para controle biológico. A combinação de clima tropical, grande extensão agrícola e pressão por soluções sustentáveis explica a vanguarda brasileira. A liderança do Brasil mostra que é possível aliar produtividade a inovação de baixo impacto ambiental. De acordo com Bettiol, o Brasil precisa trabalhar duro para manter esta importante liderança obtida à base de muito investimento na pesquisa básica de controle biológico ao longo dos anos. Necessitamos agora investir ainda mais em pesquisa e desenvolvimento e também em treinamento para que esta ferramenta também chegue até os pequenos e médios agricultores brasileiros. Precisamos urgentemente desenvolver biofungicidas para o controle da ferrugem do cafeeiro e da ferrugem asiática da soja. Também precisamos de muitas pesquisas conjuntas com as empresas para o desenvolvimento urgente de bioherbicidas.Grandes mercados agrícolas, como Estados Unidos, Europa e China, também ampliam o uso de produtos biológicos, reduzindo a dependência de químicos. A urgência climática e a exigência por alimentos mais limpos impulsionam essa virada.O uso de bioinsumos reduz resíduos químicos no solo e na água, preserva a biodiversidade e diminui emissões de gases de efeito estufa. Economicamente, representa menor custo a longo prazo e menor risco de resistência de pragas. Socialmente, estimula cadeias locais de produção e uso de tecnologias adaptadas à agricultura familiar. |
Cristina Tordin (MTb 28.499/SP)
Embrapa Meio Ambiente
Contatos para a imprensa
meio-ambiente.imprensa@embrapa.br
Telefone: (19) 3311-2608